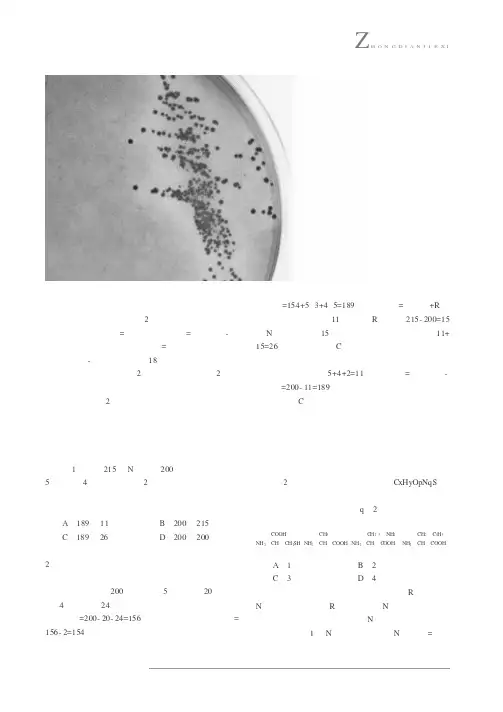

有关蛋白质中的计算题归类分析_New
- 格式:doc
- 大小:4.70 MB
- 文档页数:6

有关蛋白质中得计算题归类分析蛋白质就是生命活动得主要承担者,对生物体得结构与功能具有十分重要得意义。
蛋白质得形成过程就是:由许多个氨基酸分子通过脱水缩合互相连接而成多肽,因多肽通常呈链状结构,又称肽链。
一个蛋白质分子可以含有一条或几条肽链,肽链通过一定得化学键连接在一起,形成具有一定空间结构得蛋白质、蛋白质中氨基酸数、氨基数、羧基数、肽链数、肽键数、脱水数、分子量等各因素之间得数量关系就是高考得必考点,因此,对蛋白质中有关数量得计算题应重点关注。
本文结合教学实践,对有关蛋白质计算题得作归类例析、题型1有关蛋白质中氨基酸分子式得计算【典例1】(分子式C10H17O6N3S)就是存在于动植物与微生物细胞中得一个重要三肽,它就是由谷氨酸(C3H9O4N)、甘氨酸(C2H5O2N)与半胱氨酸缩合而成,则半胱氨酸可能得分子式为A、C3H3NS B.C3H5ONS C.C3H7O2NS D.C3H3O2NS题型2 有关蛋白质中肽键数及脱下水分子数得计算【典例2】某肽链由51个氨基酸组成,如果用肽酶把其分解成1个二肽、2个五肽、3个六肽、3个七肽,则这些短肽得氨基酸总数得最小值、肽键总数、分解成这些小分子肽所需水分子总数依次就是题型3有关蛋白质中游离得氨基或羧基数目得计算【典例3】一个蛋白质分子有三条肽链构成,共有366个氨基酸,则这个蛋白质分子至少含有得氨基与羧基数目分别就是A、366与366B、365与363 C.363与363 D.3与3题型4 有关蛋白质种类得计算【典例4】如果有足量得三种氨基酸,分别为A、B、C,则它们能形成得三肽种类以及包含三种氨基酸得三肽种类分别最多有( )A。
9种,9种B.6种,3种C。
18种,6种D.27种,6种题型5氨基酸中得各原子得数目计算【典例5】谷氨酸得R基为—C3H5O2,一分子谷氨酸含有得C、H、O、N原子数依次就是( )A、5、9、4、1 B.4、8、5、1 C.5、8、4、1 D.4、9、4、1题型6 利用化学平衡计算氨基酸数目【典例6】称取某多肽415g,在小肠液得作用下完全水解得到氨基酸505g、经分析知道组成此多肽得氨基酸平均相对分子质量为100,此多肽由甘氨酸、丙氨酸、半胱氨酸3种氨基酸组成,每摩尔此多肽含有S元素51mol、3种氨基酸得分子结构式如下:组成一分子得此多肽需氨基酸个数就是多少?题型7 水解产物中个别氨基酸得个数【典例7】有一条多肽链由12个氨基酸组成,分子式为CxHyNzOwS(z>12,w〉13),这条多肽链经过水解后得产物中有5种氨基酸:半胱氨酸(C3H7NO2S)、丙氨酸(C3H6NO2)、天门冬氨酸(C4H7N04)、赖氨酸(C6H14N202)、苯丙氨酸(C9H11NO2)。

重点解析Z H O N G D I A N J I E X I在蛋白质类的计算问题中,关于蛋白质类的公式其实并不多,主要的公式有2个:一个是“肽键数=脱去的水分子数=氨基酸数-肽链数”;另一个是“蛋白质分子量=氨基酸总数×氨基酸平均分子量-脱去水分子数×18”。
当然,要熟练掌握这2个公式,首先明确这2个公式是如何推导出来的,要“知其然并知其所以然”,只有充分理解了这2个公式,才能做到灵活运用。
另外,对“蛋白质的结构”的掌握也要做到胸有成竹,很多计算问题是与之相辅相成的。
一、明确氨基酸数量巧计算例1含有215个N原子的200个氨基酸,形成了5个四肽、4个六肽和一个2条肽链构成的蛋白质分子。
这些多肽和蛋白质分子中,肽键与氨基数目的最大值分别是()A.189和11B.200和215C.189和26D.200和200解析首先在审题时要注意,形成的最后一个是2条肽链构成的蛋白质分子,不是一个二肽,这个蛋白质是几肽并不知道,但这个蛋白质分子含有的氨基酸数可以算出来,共200个氨基酸,5个四肽有20个氨基酸,4个六肽有24个氨基酸。
因此,该蛋白质含有的氨基酸数=200-20-24=156。
该蛋白质含有的肽键数= 156-2=154个。
综上所述,这些多肽和蛋白质共有的肽键数=154+5×3+4×5=189。
氨基数目=肽链数+R基中的氨基酸,肽链数11条,考虑R基中共215-200=15个N,氨基数最多15个,因此,氨基总数最大值是11+ 15=26个。
因此,答案C。
其实,这个题的第一问可以巧算:如果将四肽和六肽都理解为肽链,则这些多肽和蛋白质分子共有5+4+2=11条,肽键数=氨基酸数-肽链数=200-11=189。
答案C点拨本题考察的是基本功,也考察大家灵活运用公式的能力,如果公式理解透彻,则可在短时间内即可突破该题。
二、多肽链计算应小心例2有一条多肽链,分子式为CxHyOpNqS,将它彻底水解后,只得到下列四种氨基酸。


(完整版)高中生物必修一蛋白质的计算题归析高中生物必修一蛋白质的计算题归析(灵璧中学)1.有关蛋白质相对分子质量的计算例1组成生物体某蛋白质的20种氨基酸的平均相对分子质量为128,一条含有100个肽键的多肽链的分子量为多少?解析:在解答这类问题时,必须明确的基本关系式是:蛋白质的相对分子质量=氨基酸数×氨基酸的平均相对分子质量?脱水数×18(水的相对分子质量)本题中含有100个肽键的多肽链中氨基酸数为:100+1=101,肽键数为100,脱水数也为100,则依上述关系式,蛋白质分子量=101×128?100×18=11128。
变式1:组成生物体某蛋白质的20种氨基酸的平均相对分子质量为128,则由100个氨基酸构成的含2条多肽链的蛋白质,其分子量为()A.12800B.11018C.11036D.8800解析:对照关系式,要求蛋白质分子量,还应知道脱水数。
由于题中蛋白质包含2条多肽链,所以,脱水数=100?2=98,所以,蛋白质的分子量=128×100?18×98=11036,答案为C。
变式2:全世界每年有成千上万人由于吃毒蘑菇而身亡,其中鹅膏草碱就是一种毒菇的毒素,它是一种环状八肽。
若20种氨基酸的平均分子量为128,则鹅膏草碱的分子量约为( ) A.1024 B.898 C.880 D.862解析:所谓环肽即指由首尾相接的氨基酸组成的环状的多肽,其特点是肽键数与氨基酸数相同。
所以,鹅膏草碱的分子量=8 ×128?8 ×18=880,答案为C。
2.有关蛋白质中氨基酸数、肽链数、肽键数、脱水数的计算在解答这类问题时,必须明确的基本知识是蛋白质中氨基酸数、肽链数、肽键数、脱水数的数量关系。
基本关系式有:n个氨基酸脱水缩合形成一条多肽链,则肽键数=(n?1)个;n个氨基酸脱水缩合形成m条多肽链,则肽键数=(n?m)个;无论蛋白质中有多少条肽链,始终有:脱水数=肽键数=氨基酸数?肽链数例2氨基酸分子缩合形成含2条肽链的蛋白质分子时,相对分子量减少了900,由此可知,此蛋白质分子中含有的氨基酸数和肽键数分别是()A.52、52B.50、50C.52、50D.50、49解析:氨基酸分子形成蛋白质时相对分子质量减少的原因是在此过程中脱去了水,据此可知,肽键数=脱水数=900÷18=50,依上述关系式,氨基酸数=肽键数+肽链数=50+2=52,答案为C。

有关蛋白质中的计算题归类分析蛋白质的形成过程是:由许多个氨基酸分子通过脱水缩合互相连接而成多肽,因多肽通常呈链状结构,又称肽链。
一个蛋白质分子可以含有一条或几条肽链,肽链通过一定的化学键连接在一起,形成具有一定空间结构的蛋白质。
蛋白质中氨基酸数、氨基数、羧基数、肽链数、肽键数、脱水数、分子量等各因素之间的数量关系是高考的必考点,题型1 有关蛋白质中氨基酸分子式的计算?【典例1】(分子式C10H17O6N3S)是存在于动植物和微生物细胞中的一个重要三肽,它是由谷氨酸(C5H9O4N)、甘氨酸(C2H5O2N)和半胱氨酸缩合而成,则半胱氨酸可能的分子式为A.C3H3NS B.C3H5ONS C.C3H7O2NS D.C3H3O2NS题型2 有关蛋白质中肽键数及脱下水分子数的计算【典例2】某肽链由51个氨基酸组成,如果用肽酶把其分解成1个二肽、2个五肽、3个六肽、3个七肽,则这些短肽的氨基总数的最小值、肽键总数、分解成这些小分子肽所需水分子总数依次是()C (9, 42, 8=50-42)题型3 有关蛋白质中游离的氨基或羧基数目的计算【例3】一个蛋白质分子有三条肽链构成,共有366个氨基酸,则这个蛋白质分子至少含有的氨基和羧基数目是A.366和366 B.365和363 C.363和363 D.3和3题型4 有关蛋白质种类的计算【例4】如果有足量的三种氨基酸,分别为A、B、C,则它们能形成的三肽种类以及包含三种氨基酸的三肽种类分别最多有()A .9种,9种B .6种,3种C .18种,6种D .27种,6种题型5 氨基酸中的各原子的数目计算【例5】谷氨酸的R 基为—C3H 5O 2,一分子谷氨酸含有的C 、H 、O 、N 原子数依次是( )A .5、9、4、1B .4、8、5、1C .5、8、4、1D .4、9、4、1题型6 利用化学平衡计算氨基酸数目【例6】称取某多肽415g ,在小肠液的作用下完全水解得到氨基酸505g 。

咐呼州鸣咏市呢岸学校蛋白质计算题型归类解析中学225711 胡月辉计算题是生物试题中常见题型之一。
蛋白质中氨基酸、氨基、羧基、肽链、肽键、脱水数、分子量、核苷酸1.有关蛋白质相对分子质量的计算例1组成生物体某蛋白质的20种氨基酸的平均相对分子质量为128,一条含有100个肽键的多肽链的分子量为多少?解析:在解答这类问题时,必须明确的基本关系式是:蛋白质的相对分子质量=氨基酸数×氨基酸的平均相对分子质量−脱水数×18(水的相对分子质量)本题中含有100个肽键的多肽链中氨基酸数为:100+1=101,肽键数为100,脱水数也为100,则依上述关系式,蛋白质分子量=101×128−100×18=8。
变式1:组成生物体某蛋白质的20种氨基酸的平均相对分子质量为128,则由100个氨基酸构成的含2条多肽链的蛋白质,其分子量为()A. 12800B. 11018C. 11036D. 8800解析:对照关系式,要求蛋白质分子量,还知道脱水数。
由于题中蛋白质包含2条多肽链,所以,脱水数=100−2=98,所以,蛋白质的分子量=128×100−18×98=11036,答案为C。
变式2:全每年有成千上万人由于吃毒蘑菇而身亡,其中鹅膏草碱就是一种毒菇的毒素,它是一种环状八肽。
若20种氨基酸的平均分子量为128,则鹅膏草碱的分子量约为( )A. 1024 B. 898C. 880 D. 862解析:所谓环肽即指由首尾相接的氨基酸组成的环状的多肽,其特点是肽键数与氨基酸数相同。
所以,鹅膏草碱的分子量=8 ×128−8 ×18=880,答案为C。
2.有关蛋白质中氨基酸数、肽链数、肽键数、脱水数的计算在解答这类问题时,必须明确的基本知识是蛋白质中氨基酸数、肽链数、肽键数、脱水数的数量关系。
基本关系式有:n个氨基酸脱水缩合形成一条多肽链,则肽键数=(n−1)个;n个氨基酸脱水缩合形成m条多肽链,则肽键数=(n−m)个;无论蛋白质中有多少条肽链,始终有:脱水数=肽键数=氨基酸数−肽链数例2氨基酸分子缩合形成含2条肽链的蛋白质分子时,相对分子量减少了900,由此可知,此蛋白质分子中含有的氨基酸数和肽键数分别是()A. 52、52B. 50、50C. 52、50D. 50、49解析:氨基酸分子形成蛋白质时相对分子质量减少的原因是在此过程中脱去了水,据此可知,肽键数=脱水数=900÷18=50,依上述关系式,氨基酸数=肽键数+肽链数=50+2=52,答案为C。

高中生物必修一蛋白质的计算题归析(灵璧中学)1.有关蛋白质相对分子质量的计算例1组成生物体某蛋白质的20种氨基酸的平均相对分子质量为128,一条含有100个肽键的多肽链的分子量为多少?解析:在解答这类问题时,必须明确的基本关系式是:蛋白质的相对分子质量=氨基酸数×氨基酸的平均相对分子质量?脱水数×18(水的相对分子质量)本题中含有100个肽键的多肽链中氨基酸数为:100+1=101,肽键数为100,脱水数也为100,则依上述关系式,蛋白质分子量=101×128?100×18=11128。
变式1:组成生物体某蛋白质的20种氨基酸的平均相对分子质量为128,则由100个氨基酸构成的含2条多肽链的蛋白质,其分子量为()A.12800B.11018C.11036D.8800解析:对照关系式,要求蛋白质分子量,还应知道脱水数。
由于题中蛋白质包含2条多肽链,所以,脱水数=100?2=98,所以,蛋白质的分子量=128×100?18×98=11036,答案为C。
变式2:全世界每年有成千上万人由于吃毒蘑菇而身亡,其中鹅膏草碱就是一种毒菇的毒素,它是一种环状八肽。
若20种氨基酸的平均分子量为128,则鹅膏草碱的分子量约为( ) A.1024 B.898C.880 D.862解析:所谓环肽即指由首尾相接的氨基酸组成的环状的多肽,其特点是肽键数与氨基酸数相同。
所以,鹅膏草碱的分子量=8 ×128?8 ×18=880,答案为C。
2.有关蛋白质中氨基酸数、肽链数、肽键数、脱水数的计算在解答这类问题时,必须明确的基本知识是蛋白质中氨基酸数、肽链数、肽键数、脱水数的数量关系。
基本关系式有:n个氨基酸脱水缩合形成一条多肽链,则肽键数=(n?1)个;n个氨基酸脱水缩合形成m条多肽链,则肽键数=(n?m)个;无论蛋白质中有多少条肽链,始终有:脱水数=肽键数=氨基酸数?肽链数例2氨基酸分子缩合形成含2条肽链的蛋白质分子时,相对分子量减少了900,由此可知,此蛋白质分子中含有的氨基酸数和肽键数分别是()A.52、52B.50、50C.52、50D.50、49解析:氨基酸分子形成蛋白质时相对分子质量减少的原因是在此过程中脱去了水,据此可知,肽键数=脱水数=900÷18=50,依上述关系式,氨基酸数=肽键数+肽链数=50+2=52,答案为C。

蛋白质计算问题归类解析标号(一)计算题是生物试题中常见题型之一。
蛋白质中氨基酸、氨基、羧基、肽链、肽键、脱水数、分子量等各因素之间数量关系复杂,为生物计算题型的命题提供了很好的素材。
现对此归类如下:一、有关蛋白质相对分子质量的计算在解答这类问题时,必须明确的基本关系式是:蛋白质的相对分子质量=氨基酸数×氨基酸的平均相对分子质量−脱水数×18(水的相对分子质量)。
比如有m个氨基酸,形成n个肽链,每个氨基酸的平均相对分子质量为a,那么,由此形成的蛋白质相对分子质量为:m·a一(m—n)·18 [其中(m—n)为失去的水分子数,18为水的相对分子质量]。
(注:有时还要考虑一些其他化学变化过程.如二硫键(一s—s)形成等)1、组成生物体某蛋白质的20种氨基酸的平均相对分子质量为128,则由100个氨基酸构成的含2条多肽链的蛋白质,其分子量为()A.12800B.11018C.11036D.88002、氨基酸分子缩合形成含2条肽链的蛋白质分子时,相对分子量减少了900,由此可知,此蛋白质分子中含有的氨基酸数和肽键数分别是()A.52、52 B.50、50 C.52、50 D.50、493、若某蛋白质的分子量为11935,在合成这个蛋白质分子的过程中脱水量为1908,假设氨基酸的平均分子量为127,则组成该蛋白质分子的肽链有()A.1条 B.2条 C.3条 D.4条4、某蛋白质分子含有a条肽链,共有b个氨基酸。
如果氨基酸的平均相对分子质量是c,则该蛋白质的相对分子质量以及水解时需要的水的相对分子质量分别是()A.b(c-18)+18a和18(b—a) B.b(c+18)+18a和18(a + b)C.b(c-18)—18a和18(a—b) D.b(c+18)—18a和18(b—a)5、全世界每年有成千上万人由于吃毒蘑菇而身亡,其中鹅膏蕈碱就是一种毒菇的毒素,它是一种环状八肽。


高中生物必修一蛋白质的计算题归析(灵璧中学)1.有关蛋白质相对分子质量的计算例1组成生物体某蛋白质的20种氨基酸的平均相对分子质量为128,一条含有100个肽键的多肽链的分子量为多少?解析:在解答这类问题时,必须明确的基本关系式是:蛋白质的相对分子质量=氨基酸数×氨基酸的平均相对分子质量?脱水数×18(水的相对分子质量)本题中含有100个肽键的多肽链中氨基酸数为:100+1=101,肽键数为100,脱水数也为100,则依上述关系式,蛋白质分子量=101×128?100×18=11128。
变式1:组成生物体某蛋白质的20种氨基酸的平均相对分子质量为128,则由100个氨基酸构成的含2条多肽链的蛋白质,其分子量为()A.12800B.11018C.11036D.8800解析:对照关系式,要求蛋白质分子量,还应知道脱水数。
由于题中蛋白质包含2条多肽链,所以,脱水数=100?2=98,所以,蛋白质的分子量=128×100?18×98=11036,答案为C。
变式2:全世界每年有成千上万人由于吃毒蘑菇而身亡,其中鹅膏草碱就是一种毒菇的毒素,它是一种环状八肽。
若20种氨基酸的平均分子量为128,则鹅膏草碱的分子量约为( )A.1024 B. 898C.880 D. 862解析:所谓环肽即指由首尾相接的氨基酸组成的环状的多肽,其特点是肽键数与氨基酸数相同。
所以,鹅膏草碱的分子量=8 ×128?8 ×18=880,答案为C。
2.有关蛋白质中氨基酸数、肽链数、肽键数、脱水数的计算在解答这类问题时,必须明确的基本知识是蛋白质中氨基酸数、肽链数、肽键数、脱水数的数量关系。
基本关系式有:n个氨基酸脱水缩合形成一条多肽链,则肽键数=(n?1)个;n个氨基酸脱水缩合形成m条多肽链,则肽键数=(n?m)个;无论蛋白质中有多少条肽链,始终有:脱水数=肽键数=氨基酸数?肽链数例2氨基酸分子缩合形成含2条肽链的蛋白质分子时,相对分子量减少了900,由此可知,此蛋白质分子中含有的氨基酸数和肽键数分别是()A.52、52B.50、50C.52、50D.50、49解析:氨基酸分子形成蛋白质时相对分子质量减少的原因是在此过程中脱去了水,据此可知,肽键数=脱水数=900÷18=50,依上述关系式,氨基酸数=肽键数+肽链数=50+2=52,答案为C。
与蛋白质相关的计算题型及解法王玉红(河北省张家口市第二中学 075000)蛋白质是构成生物体的重要化合物,又是生命活动的体现者。
因此,蛋白质是高中《生物》中的重点和难点,也是考点和热点。
现将与蛋白质相关的计算题型及解法做了如下的小结和归纳。
1 与氨基酸缩合反应有关的计算1. 1 关于缩合反应过程中氨基酸的个数、肽链数、形成的肽键个数和脱去的水分子数之间的数量关系见例1 ~ 3。
例1:血红蛋白的分子中,含有574 个氨基酸和四条肽链,问在形成此蛋白质分子时,失去水分子数和形成的肽键个数分别是多少?解析:此种类型题是蛋白质相关计算中最基本的题型,根据组成生物体蛋白质的氨基酸的通式及氨基酸的缩合反应过程,可以总结出如下规律:氨基酸的个数- 肽链数= 脱去水分子数= 肽键数据此规律可知:肽键数= 脱去的水分子数= 574 -4 = 5701. 2 关于蛋白质相对分子质量的计算此类计算是以1. 1 为基础,结合化学反应中反应前和反应后原子数不变的原理,计算蛋白质的相对分子质量。
例2:组成生物体某蛋白质的12 种氨基酸的平均相对分子质量为128,一条含有100 个肽键的多肽链的相对分子质量为多少?解析:氨基酸合成蛋白质的过程中,要失去水分子,因此其相对分子质量变化由失去的分子数目的多少决定。
由氨基酸的缩合反应可知:氨基酸的个数×氨基酸的相对分子质量= 多肽(蛋白质)的相对分子质量+ 水分子的个数× 18(水的相对分子质量)。
则蛋白质的相对分子质量= 氨基酸的个数×氨基酸的相对分子质量- 水分子的个数× 18此多肽的相对分子质量=(100 + 1)× 128 - 100 ×18 = 12728例3. 胰岛素是一种蛋白质分子,它含有两条多肽链,A 链含有21 个氨基酸,B 链含有30 个氨基酸。
2条肽链间通过2 个二硫键(二硫键是由2 个- SH)连接而成,在A 链上也形成1 个二硫键。
高中生物必修一蛋白质计算题归析(灵璧中学)1.有关蛋白质相对分子质量计算例1组成生物体某蛋白质20种氨基酸平均相对分子质量为128,一条含有100个肽键多肽链分子量为多少?解析:在解答这类问题时,必须明确基本关系式是:蛋白质相对分子质量=氨基酸数×氨基酸平均相对分子质量?脱水数×18(水相对分子质量)本题中含有100个肽键多肽链中氨基酸数为:100+1=101,肽键数为100,脱水数也为100,则依上述关系式,蛋白质分子量=101×128?100×18=11128。
变式1:组成生物体某蛋白质20种氨基酸平均相对分子质量为128,则由100个氨基酸构成含2条多肽链蛋白质,其分子量为()A.12800B.11018C.11036D.8800解析:对照关系式,要求蛋白质分子量,还应知道脱水数。
由于题中蛋白质包含2条多肽链,所以,脱水数=100?2=98,所以,蛋白质分子量=128×100?18×98=11036,答案为C。
变式2:全世界每年有成千上万人由于吃毒蘑菇而身亡,其中鹅膏草碱就是一种毒菇毒素,它是一种环状八肽。
若20种氨基酸平均分子量为128,则鹅膏草碱分子量约为( )A.1024 B. 898C.880 D. 862解析:所谓环肽即指由首尾相接氨基酸组成环状多肽,其特点是肽键数及氨基酸数相同。
所以,鹅膏草碱分子量=8 ×128?8 ×18=880,答案为C。
2.有关蛋白质中氨基酸数、肽链数、肽键数、脱水数计算在解答这类问题时,必须明确基本知识是蛋白质中氨基酸数、肽链数、肽键数、脱水数数量关系。
基本关系式有:n个氨基酸脱水缩合形成一条多肽链,则肽键数=(n?1)个;n个氨基酸脱水缩合形成m条多肽链,则肽键数=(n?m)个;无论蛋白质中有多少条肽链,始终有:脱水数=肽键数=氨基酸数?肽链数例2氨基酸分子缩合形成含2条肽链蛋白质分子时,相对分子量减少了900,由此可知,此蛋白质分子中含有氨基酸数和肽键数分别是()A.52、52B.50、50C.52、50D.50、49解析:氨基酸分子形成蛋白质时相对分子质量减少原因是在此过程中脱去了水,据此可知,肽键数=脱水数=900÷18=50,依上述关系式,氨基酸数=肽键数+肽链数=50+2=52,答案为C。
高中生物必修一蛋白质的计算题归析(灵璧中学)1.有关蛋白质相对分子质量的计算例1组成生物体某蛋白质的20种氨基酸的平均相对分子质量为128,一条含有100个肽键的多肽链的分子量为多少?解析:在解答这类问题时,必须明确的基本关系式是:蛋白质的相对分子质量=氨基酸数×氨基酸的平均相对分子质量?脱水数×18(水的相对分子质量)本题中含有100个肽键的多肽链中氨基酸数为:100+1=101,肽键数为100,脱水数也为100,则依上述关系式,蛋白质分子量=101×128?100×18=11128。
变式1:组成生物体某蛋白质的20种氨基酸的平均相对分子质量为128,则由100个氨基酸构成的含2条多肽链的蛋白质,其分子量为()A. 12800B. 11018C. 11036D. 8800解析:对照关系式,要求蛋白质分子量,还应知道脱水数。
由于题中蛋白质包含2条多肽链,所以,脱水数=100?2=98,所以,蛋白质的分子量=128×100?18×98=11036,答案为C。
变式2:全世界每年有成千上万人由于吃毒蘑菇而身亡,其中鹅膏草碱就是一种毒菇的毒素,它是一种环状八肽。
若20种氨基酸的平均分子量为128,则鹅膏草碱的分子量约为( )A. 1024 B. 898C. 880 D. 862解析:所谓环肽即指由首尾相接的氨基酸组成的环状的多肽,其特点是肽键数与氨基酸数相同。
所以,鹅膏草碱的分子量=8 ×128?8 ×18=880,答案为C。
2.有关蛋白质中氨基酸数、肽链数、肽键数、脱水数的计算在解答这类问题时,必须明确的基本知识是蛋白质中氨基酸数、肽链数、肽键数、脱水数的数量关系。
基本关系式有:n个氨基酸脱水缩合形成一条多肽链,则肽键数=(n?1)个;n个氨基酸脱水缩合形成m条多肽链,则肽键数=(n?m)个;无论蛋白质中有多少条肽链,始终有:脱水数=肽键数=氨基酸数?肽链数例2氨基酸分子缩合形成含2条肽链的蛋白质分子时,相对分子量减少了900,由此可知,此蛋白质分子中含有的氨基酸数和肽键数分别是()A. 52、52B. 50、50C. 52、50D. 50、49解析:氨基酸分子形成蛋白质时相对分子质量减少的原因是在此过程中脱去了水,据此可知,肽键数=脱水数=900÷18=50,依上述关系式,氨基酸数=肽键数+肽链数=50+2=52,答案为C。
高中生物计算题归类解析中生物多个章节的知识与数学关系密切,在题目设计进行知识考查时,需借助数学方法来解决问题。
而且,计算题在近几年的高考试题中逐渐增加,尤其是在单科试卷中。
为培养学生应用相关数学知识分析解决生物学问题的能力,真正实现学科内知识的有机结合和跨学科知识的自然整合,现将高中生物常见计算题归类解析:1.与质白质有关的计算(1)蛋白质的肽键数=脱去水分子数=氨基酸分子数一肽链数;(2)蛋白质中至少含有的氨基(-NH2)数=至少含有羧基(-COOH)数=肽链数;(3)蛋白质的相对分子质量=氨基酸平均相对分子质量×氨基酸个数-18×脱去水分子数;(4)不考虑DNA上的无遗传效应片段、基因的非偏码区、真核细胞基因的内含子等情况时,DNA(基因)中碱基数:信使RNA中碱基数:蛋白质中氨基酸数=6:3:1 例1.某蛋白质由n条肽链组成,氨基酸的平均分子量为a,控制蛋白质合成的基因含b个碱基对,则该蛋白质的分子量约()解析:蛋白质分子量=氨基酸的分子量总和—脱去水分子质量总和。
此题关键是求氨基酸个数,由转录、翻译知识可知,基因中碱基数:mRNA碱基数:氨基酸数=6:3:1,故氨基酸数为b/3,失去水分子数为(b/3-n)。
答案:D2.物质通过生物膜层数的计算(1)1层生物膜=1层磷脂双分子层=2层磷脂分子层(2)在细胞中,核糖体、中心体、染色体无膜结构;细胞膜、液泡膜、内质网膜、高尔基体膜是单层膜;线粒体、叶绿体和细胞核的膜是双层膜,但物质是从核孔穿透核膜时,则穿过的膜层数为0。
(3)肺泡壁、毛细血管壁和消化道管壁都是由单层上皮细胞构成,且穿过1层细胞则需穿过2次细胞膜(生物膜)或4层磷脂分子层。
例2.葡萄糖经小肠粘膜上皮进入毛细血管,需透过的磷脂分子层数是()A.4层B.6层C.8层D.10层解析:葡萄糖从消化道进入毛细血管需经过上皮细胞和毛细血管壁细胞两个细胞,进出时共穿过4层膜,8层磷脂分子。
有关蛋白质中的计算题归类分析
有关蛋白质中的计算题归类分析【典例2】某肽链由51个氨基酸组成,如果用肽酶把其分解成1个二肽、2个五肽、3个六肽、3个七肽,则这些短肽的氨基酸总数的最小值、肽键总数、分解成这些小分子肽所需水分子总数依次是
题型 3 有关蛋白质中游离的氨基或羧基数目的计算
【典例3】一个蛋白质分子有三条肽链构成,共有366个氨基酸,则这个蛋白质分子至少含有的氨基和羧基数目分别是
A.366和366 B.365和363 C.363和363 D.3和3
题型4 有关蛋白质种类的计算
【典例4】如果有足量的三种氨基酸,分别为A、B、C,则它们能形成的三肽种类以及包含三种氨基酸的三肽种类分别最多有()A.9种,9种B.6种,3种 C.18种,6种 D.27种,6种
【典例6】称取某多肽415g,在小肠液的作用下完全水解得到氨基酸505g。
经分析知道组成此多肽的氨基酸平均相对分子质量为100,此多肽由甘氨酸、丙氨酸、半胱氨酸3种氨基酸组成,每摩尔此多肽含有S元素51mol。
3种氨基酸的分子结构式如下:组成一分子的此多肽需氨基酸个数是多少?
9、全世界每年有成百上千人由于吃毒蘑菇而身亡,鹅膏草碱是一种毒菇的毒素,它是一种环状八肽。
若20种氨基酸的平均分子量为128,则鹅膏草碱的分子量约为
A.1024
B.898
C.880
D.862
11. 下图为结晶牛胰岛素分子结构示意图。
已知胰岛素含有A、B两条多肽链,
A链含有21个氨基酸,B链含有30个氨基酸,两条多肽链间通过两个二硫键(二硫键由两个�SH连接而成)连接,在A链上也形成1个二硫键。
则胰岛素分子中含有的肽键数和51个氨基酸
脱水缩合形成胰岛素后,相对分子质量比原来
减少的数值各是多少()
A. 49 882
B. 49 888
C. 50 882
D. 50 888。